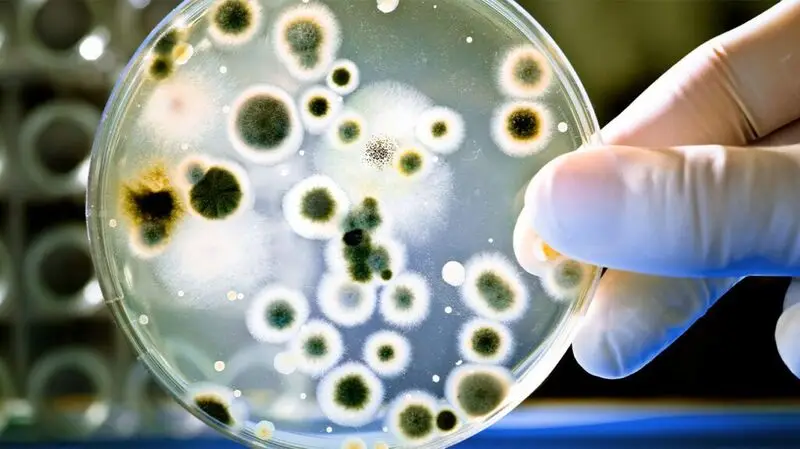
A petri dish with bacterial growth.

- Lifestyle changes, such as dietary interventions, are an effective strategy for managing type 2 diabetes by helping to control blood sugar levels.
- In addition to the type of food a person consumes, the way the food interacts with their gut microbiome may also offer protection against type 2 diabetes.
- Bacteria in the gut may produce beneficial metabolites when breaking down certain foods.
- A study suggests that a microbial molecule could block an immune pathway that triggers inflammation, which could combat insulin resistance and its complications.
Globally, diabetes affects roughly
Type 2 diabetes can develop when the body no longer responds correctly to the hormone insulin. This is known as insulin resistance. Inflammation
This resistance can increase blood sugar and insulin levels, which further fuels inflammation, creating a self-perpetuating state that drives metabolic disease such as type 2 diabetes.
The gut microbiome describes microbes living in the intestines that play an important role in overall health. Previous research highlights that the gut microbiome can profoundly influence inflammation and may trigger responses that can lead to the development of inflammatory diseases, such as diabetes.
Now, a study published in
Gut bacteria produce this metabolite from dietary choline, and it may block an immune pathway and help improve blood sugar control.
The authors of the study, consisting of researchers from University of Louvain, in Belgium, and Imperial College London, in the United Kingdom, build on
The international team observed that TMA can inhibit
Using human cell models, mouse studies, and molecular-target screening, the researchers found that TMA can directly bind to IRAK4 and block its activity, reducing diet-induced inflammation and restoring insulin sensitivity.
Speaking to Medical News Today, Michelle Routhenstein, MS, RD, CDCES, CDN, a preventive cardiology dietitian and founder of EntirelyNourished, who was not involved in the research, commented:
“The specific mechanism is new, showing that TMA can directly reduce inflammatory signaling and glycemic control, but the overall idea fits with what we already know about the choline–TMA–trimethylamine N-oxide (TMAO) pathway.”
“TMAO has long been linked with cardiovascular risk, so it is noteworthy that TMA may have protective effects when it does not get pushed toward TMAO production. This can help advance the nutrimetabolomics perspective on how gut metabolites affect cardiovascular and metabolic Health,” Routhenstein explained.
Crucially, these results indicate a direct link between gut microbial metabolism, immune regulation, and metabolic disease.
They underscore the potential role of nutrition and gut microbes in fighting inflammation and improving metabolic health.
The discovery of TMA’s ability to block this immune pathway reframes the role of the gut microbiome and its influence on immune and metabolic responses.
Identifying TMA’s anti-inflammatory properties could pave the way for new nutritional or drug-based approaches to prevent or treat insulin resistance and diabetes.
Diet remains one of the strongest modulators of gut microbiota composition and function. Previous research has shown that dietary plans rich in fiber, whole plant foods, and prebiotics may cultivate a healthy gut microbiome.
Producing beneficial metabolites, such as short-chain fatty acids (SCFAs), can help regulate glucose metabolism, suppress inflammation, and enhance insulin sensitivity.
Conversely, Western-style diets high in saturated fat and refined sugars but low in fiber are associated with microbial dysbiosis.
This describes reduced microbial diversity, lower levels of beneficial bacteria, and fewer protective metabolites, which may contribute to diabetes through inflammation and insulin resistance.
These findings may broaden the scope for nutritional interventions, highlighting that it is not just a person’s dietary pattern, but how their gut microbiome metabolizes those nutrients.
One of the study’s lead authors, Marc-Emmanuel Dumas, FRSB, FRSC, Chair in Systems Medicine and Head of the Division of Systems Medicine in the Department of Metabolism, Digestion and Reproduction at Imperial College London, noted in a press release that:
“This flips the narrative. We’ve shown that a molecule from our gut microbes can actually protect against the harmful effects of a poor diet through a new mechanism. It’s a new way of thinking about how the microbiome influences our health.”
The research team also observed that genetically deleting IRAK4 or blocking it pharmacologically produced the same beneficial effects as TMA.
This may offer a novel approach to combating insulin resistance and its complications by designing drugs to block this enzyme or boost TMA production.
Other evidence notes that IRAK4 inhibitors could be a useful therapeutic strategy against inflammatory diseases, autoimmune disorders, and cancer.
While the results of this study are promising, more human research is necessary to confirm whether increasing dietary choline and TMA from gut bacteria can improve glucose control and have no unintended effects.
Routhenstein noted that these findings could open the door for future nutritional approaches that encourage targeted probiotics, postbiotics, or personalized choline intake based on someone’s microbiome.
“For now, it supports aiming for adequate choline from whole foods while continuing to follow a high fiber, minimally processed, plant-forward eating pattern for diabetes management,” Routhenstein concluded.
At present, health experts typically recommend certain eating plans that may help manage type 2 diabetes.
For example, a meta-analysis presented at the 2025 Annual Meeting of the European Association for the Study of Diabetes (EASD) found that the AHEI, Mediterranean, and DASH diet could help reduce the risk of developing type 2 diabetes.
All three dietary plans focus on incorporating healthy fats, plant-based foods like vegetables and fruits, and reducing processed foods and those high in sugar or with added sugars.
Furthermore, a 2025 review also suggests that the DASH diet may be one of the most effective ways to reduce the risk of diabetes complications. The authors propose that his dietary plan can improve the biological pathways that drive diabetes complications.